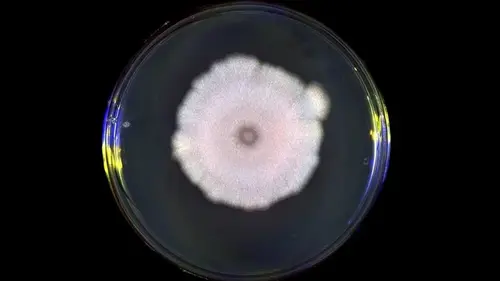
Не стоит верить всему, что говорят: дезинформацию впервые использовали вовс...

27.03.2026 в 18:18На Прикарпатье присвоили 1,5 млн на новорожденных
26.03.2026 в 20:03В Киеве вспыхнул масштабный пожар на тысячи «квадратов»
23.03.2026 в 20:28Половодье в Украине начался раньше обычного
02.04.2026 в 09:32Китай тайно наращивает свой ядерный арсенал, — CNN
31.03.2026 в 15:29В Италии можно купить дом всего за 1 евро в горах
30.03.2026 в 14:46«Белая полоса» начинается в жизни этих знаков Зодиака: кому повезет
07.03.2026 в 11:14Как получить оплату из-за границы в 2026 году: фрилансеру, ИП и компании